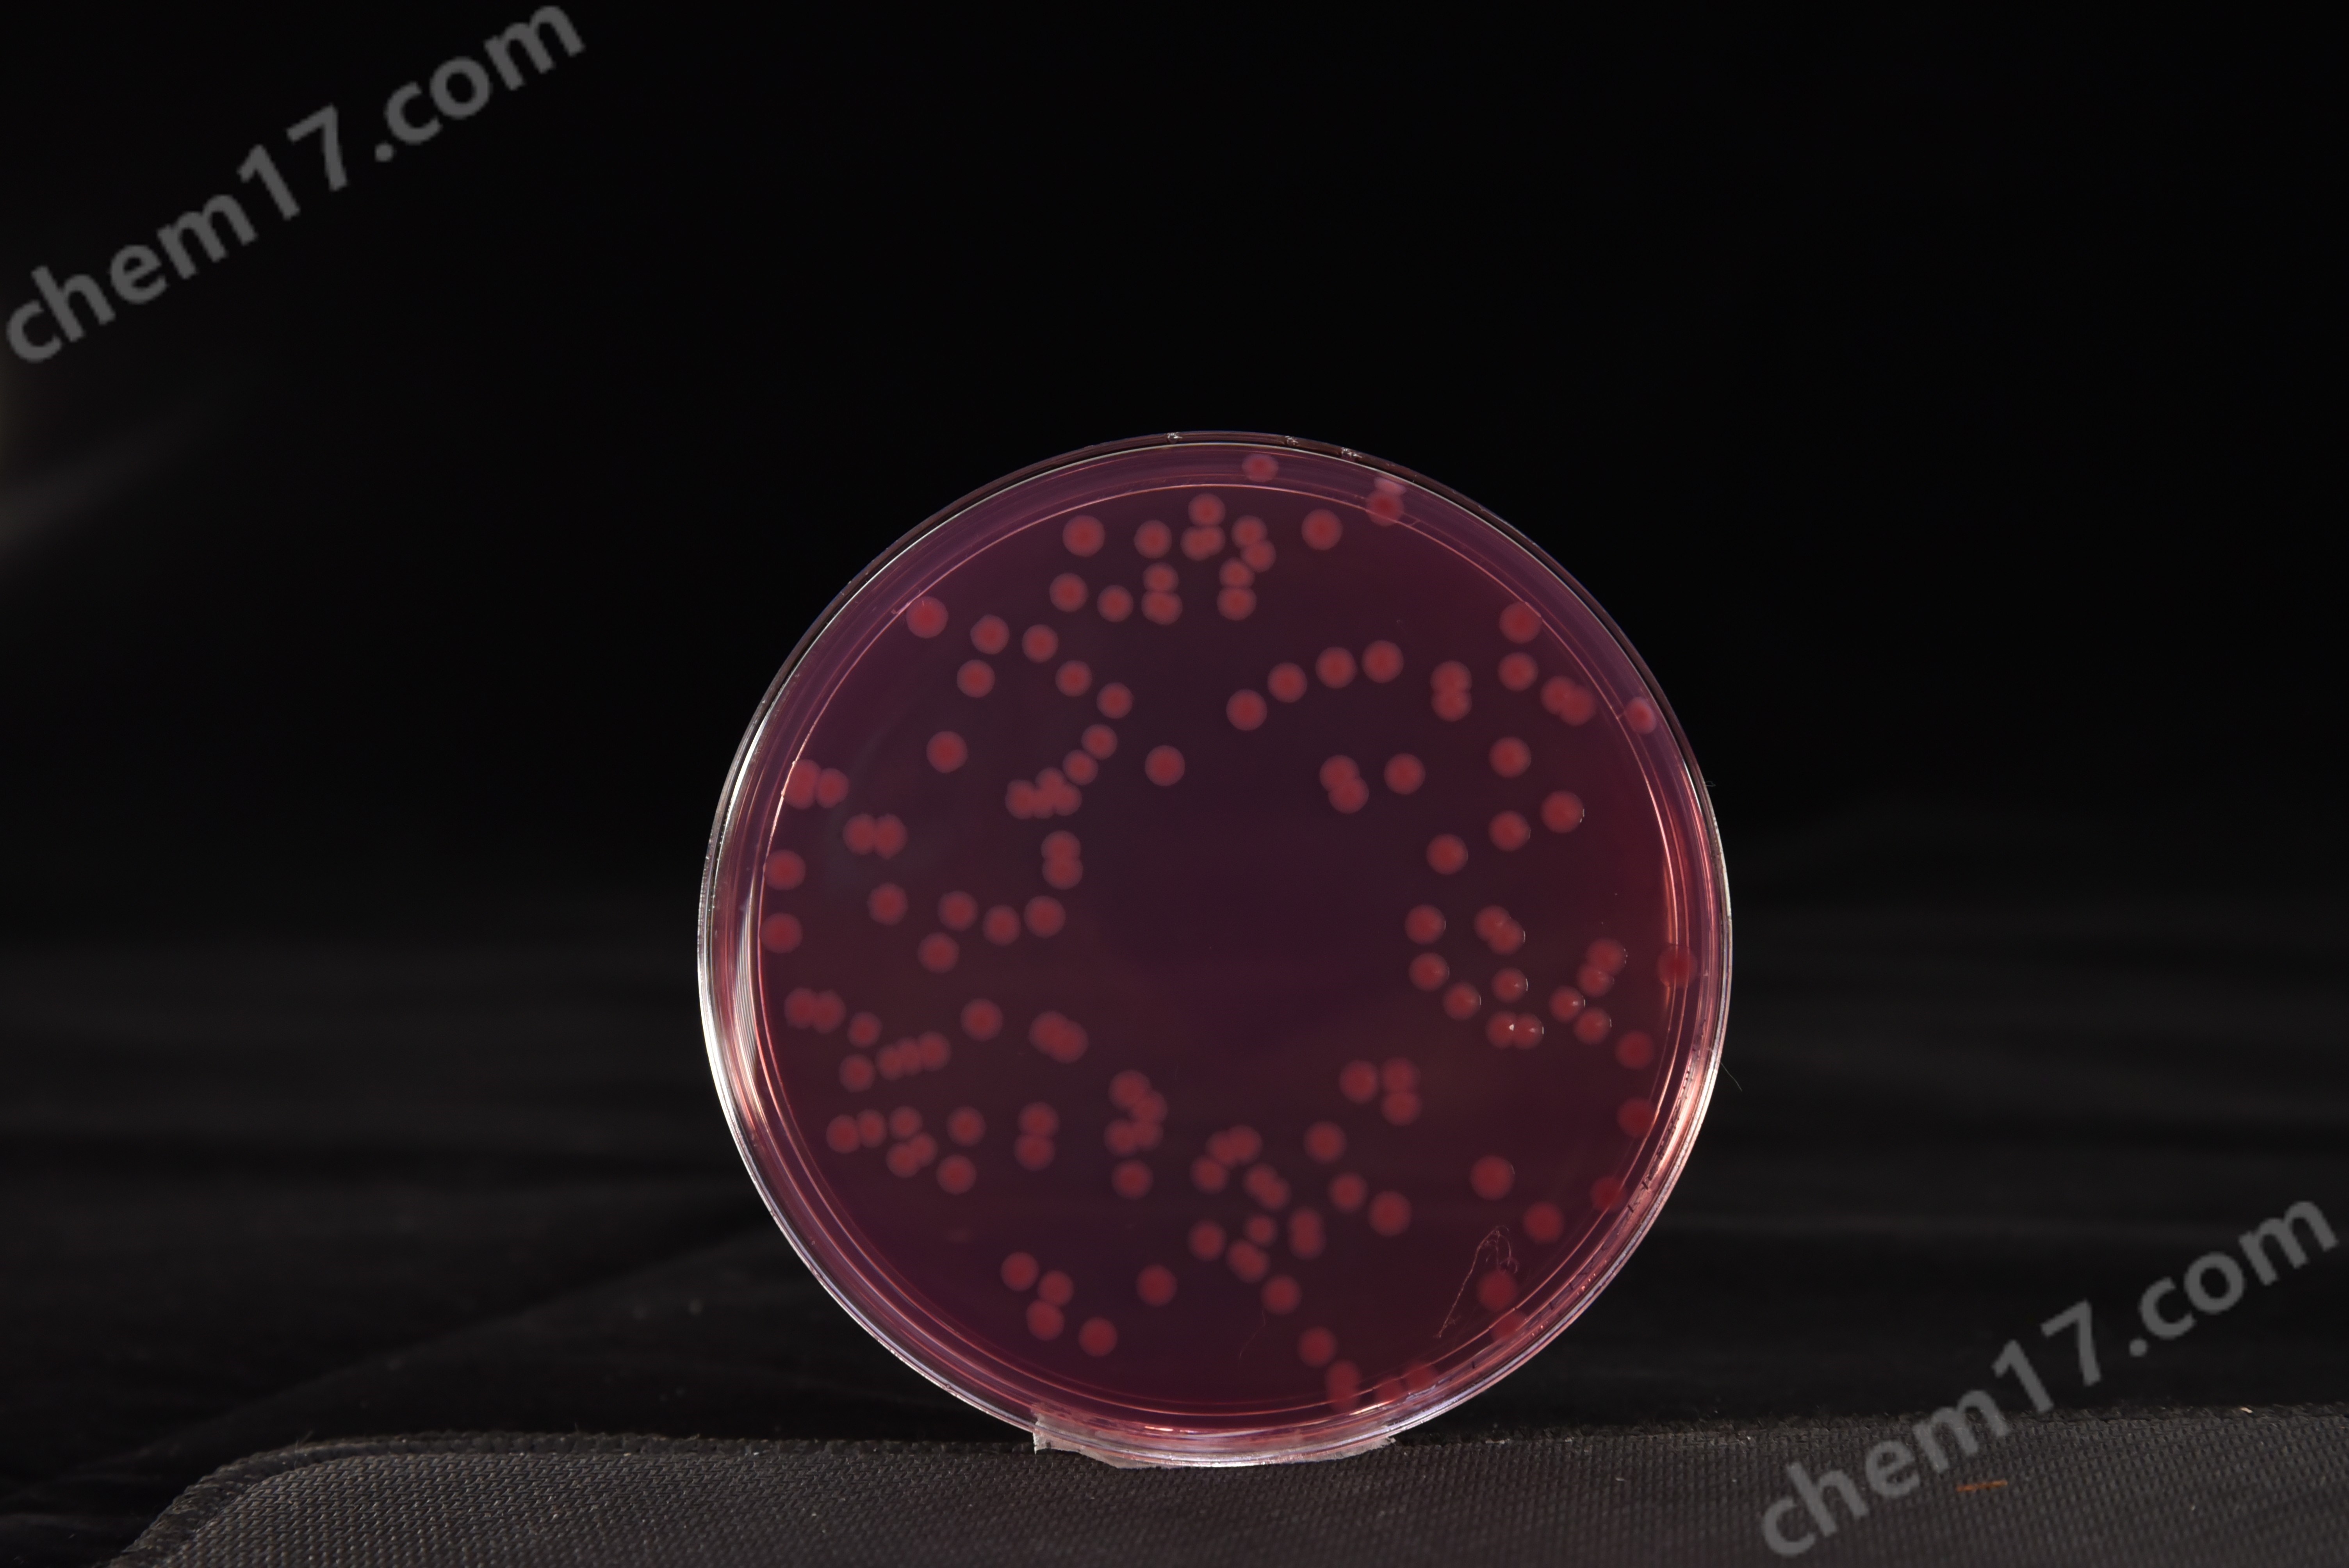
大肠杆菌O157:H7/NM菌落特征

产品展示PRODUCTS
产品名称:改良山梨-醇麦康凯(CT-SMAC)琼脂平板歌身
英文名称:CT- Sorbitol MacConkey Agar身白 Plate
其它叫(jiào)法:改良山梨-醇麦康凯琼脂平板 |&n很哥bsp;ct-smac琼脂平板
产品编号与包装规格:
| 产品编号 | 产品类型 | 包装规格 |
| CP0270B | 成(chéng)品平板 | 90mm×20个/盒 |



产品用途:用于大肠杆菌O157:H7/NM的选择性分离培养。
成(chéng) 份:蛋白胨、3号胆盐、氯化钠、琼脂、D-山梨-醇、结晶紫、中性红、抗生素、坐民蒸馏水(详细配方见說(shuō)明书)。
菌落特征:大肠杆菌O157:H7为无色、中心灰褐色的菌落。
改良山梨-醇麦康凯(CT-SMAC)琼脂平板&n還又bsp;相关产品(用于大肠埃希氏菌O157:H7/NM检验要問):
| 产品名称 | 产品货号 | 产品类型 | 规格 | 产品說(shuō)明及用途 |
|---|---|---|---|---|
| 山梨-醇麦康凯(SMAC)琼脂基础 | 025102 | 干粉基础 | 250g/瓶 | 用于致病性大肠杆菌(包括 O157:H7)的分离培一員养(SN進(jìn)出口标准) |
| 山梨-醇麦康凯(SMAC)琼脂平板 | CP0270 | 成(chéng)品平板 | 90mm×20个/盒 | |
| 月桂基硫酸盐胰蛋白胨MUG肉汤(LST-MUG) | 022211 | 干粉 | 250g/瓶 | 用于致病性大肠杆菌(包括O157:H7)的鉴别性试验(工電GB 4789.36-2016) |
| LST-MUG肉汤(月桂基硫酸盐我厭胰蛋白胨肉汤-MUG) | 022515B | 管装液体 | 10mL×20支/盒 | |
| 三糖铁琼脂(TSI)培养基 | 022080 | 干粉 | 250g/瓶 | 用于鉴别肠道(dào)菌發(fā)酵蔗糖、乳糖、葡萄糖及产生硫-化氢的生劇物化反应(GB 4789.4-2016) |
| TSI琼脂斜面(miàn)(三糖铁培养基) | CP0080 | 管装斜面(miàn) | 10mL×20支/盒 | |
| 大肠埃希氏菌O157显色培养基 | CRM007 | 干粉 | 1000mL/瓶 | 用于大肠杆菌O157:H7的快速分文但离和鉴定 |
| 大肠埃希氏菌O157显色平板 | CRM007B | 成(chéng)品平板 | 90mm×20个/盒 | |
| EasyID大肠埃希氏菌O157:H7姐小/NM生化鉴定盒 | HKI006 | 试剂盒 | 13项×10套/盒 | 用于大肠埃希氏菌O157:H7/NM的生化鉴定(GB 4789線厭.36) |
| 大肠杆菌O157:H7核酸检测试剂盒(PCR-荧光探针法) | FZ009BF2 | 分子试剂盒 | 48tests/盒 | 用于食品中大肠埃希氏菌O157:H7的检测(GB 4789慢校.36) |
| 改良EC肉汤(mEC+n)基础 | 028112 | 干粉基础 | 250g/瓶 | 用于致病性大肠杆菌O157:H吃南7的增菌培养(GB 4789.嗎紅36-2016) |
| 改良EC肉汤(mEC+n)培养基 | CP0720 | 袋装成(chéng)品 | 225mL×10袋/盒 | |
| 改良麦康凯(CT-MAC)肉汤西請基础 | 025108 | 干粉基础 | 250g/瓶 | 用于大肠埃希氏菌0157:H7/NM的选择性增菌培养(GB 4789.36市習-2008) |
| 改良山梨-醇麦康凯(CT-SMAC)琼脂基础 | 025106 | 干粉基础 | 250g/瓶 | 用于致病性大肠杆菌(包括O157:H7)的分离土吧培养(GB 4789.36-2016) |

改良山-梨醇麦康凯(CT-SMAC)琼脂平板培养基用于大肠杆菌O157:H7/NM的选择性分离培爸訊养。
改良山-梨醇麦康凯(CT-SMAC)琼脂平板培养基用于大肠杆菌O157:H7/NM的选择性分离培养。






